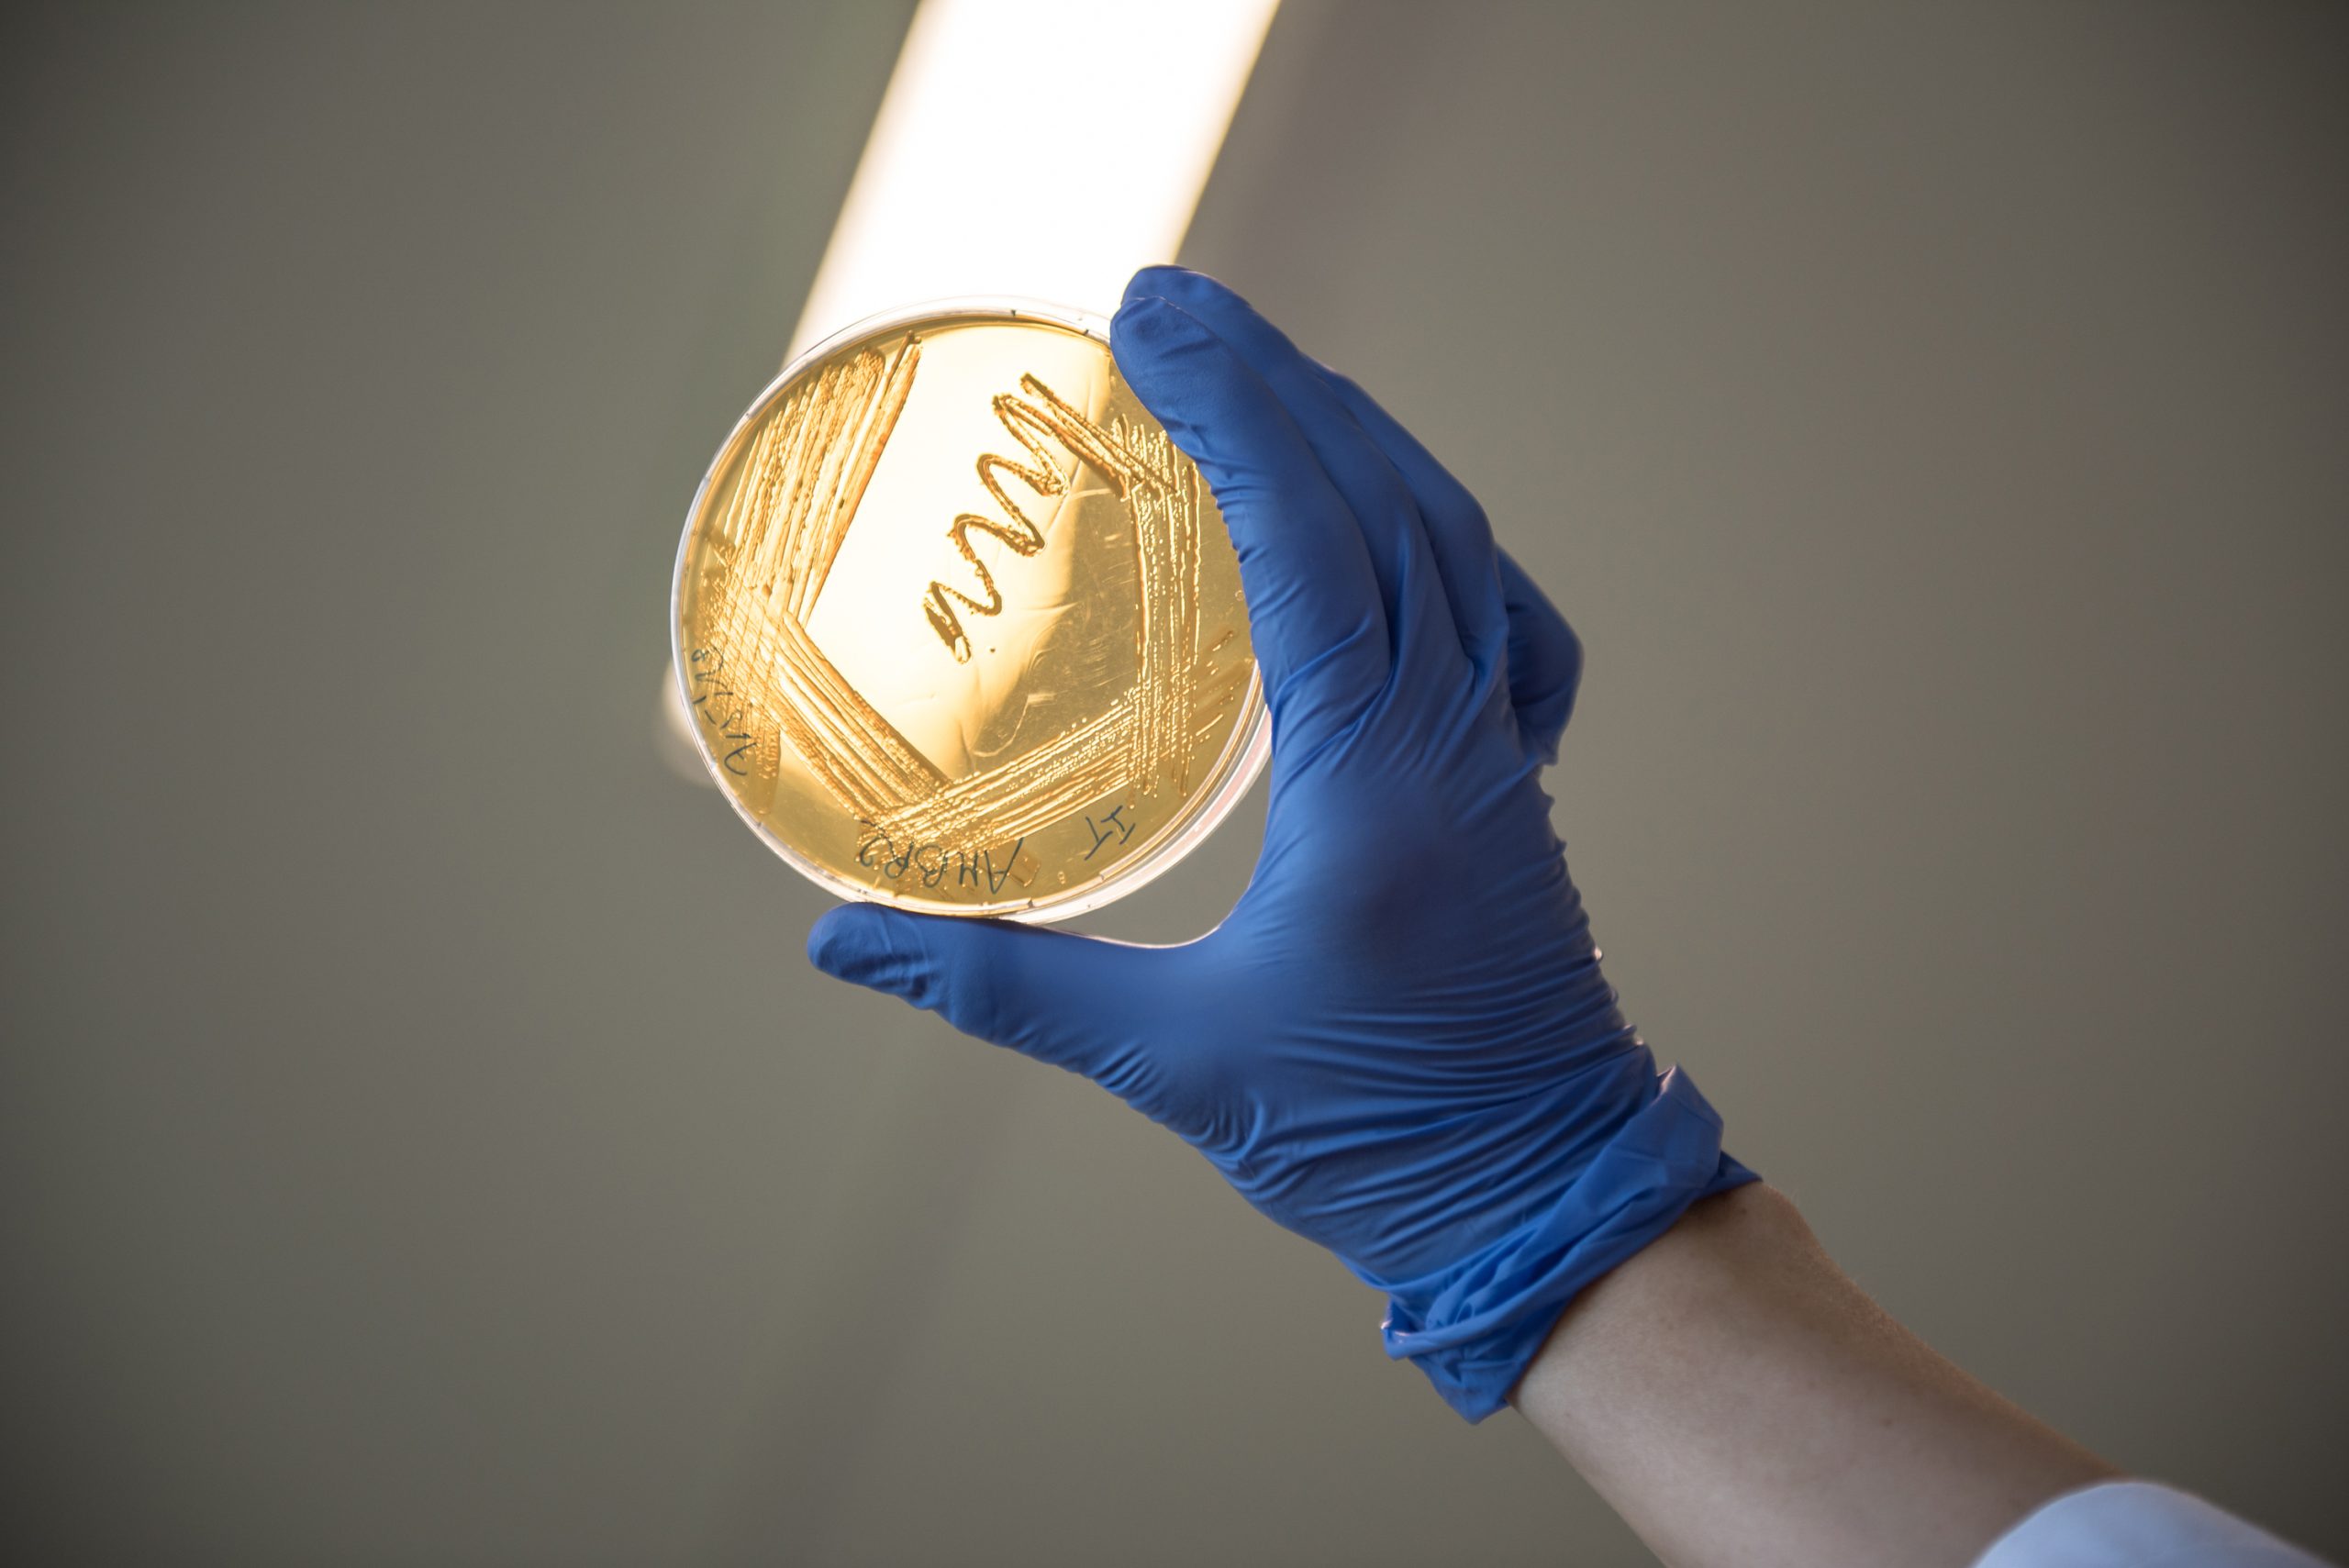
ISAPP LAB 043 scaled

ISAPP is your source for science-based resources, created and reviewed by experts in the field.
Looking for information you can trust on probiotics, prebiotics, synbiotics, postbiotics, fermented foods and more? Check out ISAPP’s resources for a wealth of accessible, reliable information specific to the field, and search according to the format or topic you need.
1-18 of 18 results
-

Highlighted Posters from the 2025 ISAPP Annual Meeting
In this second special episode about ISAPP’s annual meeting, held in Banff (Canada) in July 2025, Executive Director Marla Cunningham introduces the four highest-scoring posters from the poster session. Four speakers, all members of the ISAPP Students and Fellows association (SFA), join the podcast to describe the work they presented via poster at the meeting:… -

Fermented Food Microbiology Researcher in Mohali, India Receives 2024 Gregor Reid Award for Outstanding Scholars in Developing Nations
ISAPP’s board of directors is happy to announce the 2024 winner of the Gregor Reid Award for Outstanding Scholars in… -

Supercharging innovation: New session at ISAPP 2023 annual meeting brings industry and student members together to scientific innovation workshop in the field of biotics
Innovation in the biotics field is an important way to address some of our most important challenges in health, and… -

What is a strain in microbiology and why does it matter?
By Prof. Colin Hill, Microbiology Department and APC Microbiome Ireland, University College Cork, Ireland At the recent ISAPP meeting in… -

Mini-tutorial on statistical analysis: Correcting a common misinterpretation of p-values
Daniel Tancredi PhD, Professor of Pediatrics, UC Davis School of Medicine and Center for Healthcare Policy and Research, Sacramento, CA…. -

ISAPP’s 2021 year in review
By Mary Ellen Sanders, PhD, ISAPP Executive Science Officer The upcoming year-end naturally leads us to reflect about what has… -

Should the concept of postbiotics make us see probiotics from a new perspective?
By Dr. Gabriel Vinderola, PhD, Associate Professor of Microbiology at the Faculty of Chemical Engineering from the National University of… -

Using probiotics to support digestive health for dogs
By Kelly S. Swanson, PhD, The Kraft Heinz Company Endowed Professor in Human Nutrition, University of Illinois at Urbana-Champaign, USA… -
The future is microbial: A post-pandemic focus on identifying microbes and metabolites that support health
By Prof. Maria Marco, Department of Food Science and Technology, University of California Davis, USA The COVID-19 pandemic has been… -

‘Probiotic’ on food labels in Europe: Spain adopts a pioneering initiative
By Silvia Bañares, PhD in commercial law, attorney Barcelona Bar Association, Spain; and Miguel Gueimonde, Departamento de MicrobiologÃa y BioquÃmica de… -

Early career researchers discuss the future of probiotics and prebiotics in the first ISAPP-SFA paper
By Irina Spacova, ISAPP-SFA 2019 President and postdoctoral fellow at the University of Antwerp, Belgium Early career scientists play a… -

Connecting with the ISAPP community: Continuing to advance the science of probiotics and prebiotics
By Mary Ellen Sanders PhD, executive science officer, ISAPP On behalf of the ISAPP board of directors, I am reaching… -

ISAPP Students and Fellows Association announce blog posting: A new way to share our work and perspectives
By Anna-Ursula Happel, president ISAPP-SFA and postdoctoral fellow at the Faculty of Health Sciences at the University of Cape Town,… -

Reflections on a career in probiotic science, from ISAPP founding board member Prof. Gregor Reid
Past President and founding board member Prof. Gregor Reid is stepping down from the ISAPP Board in Banff in June… -

ISAPP’s First Meeting in Asia is a Huge Success
June 5-7th 2018 ISAPP held its first Asian meeting in Singapore. This open registration meeting was a huge success with… -

Reid Named Fellow of Royal Society of Canada
Prof. Gregor Reid, PhD, a founding board member of ISAPP, a former President of ISAPP and the current advisor to… -
January 13, 2011
Regulatory issues that impact the probiotic and prebiotic fields seem to be an overriding concern of late. In Europe, EFSA’s… -
March 31, 2010
At the 7th annual meeting of ISAPP this past November, a student/fellow association (SFA) of ISAPP was founded. Under the…